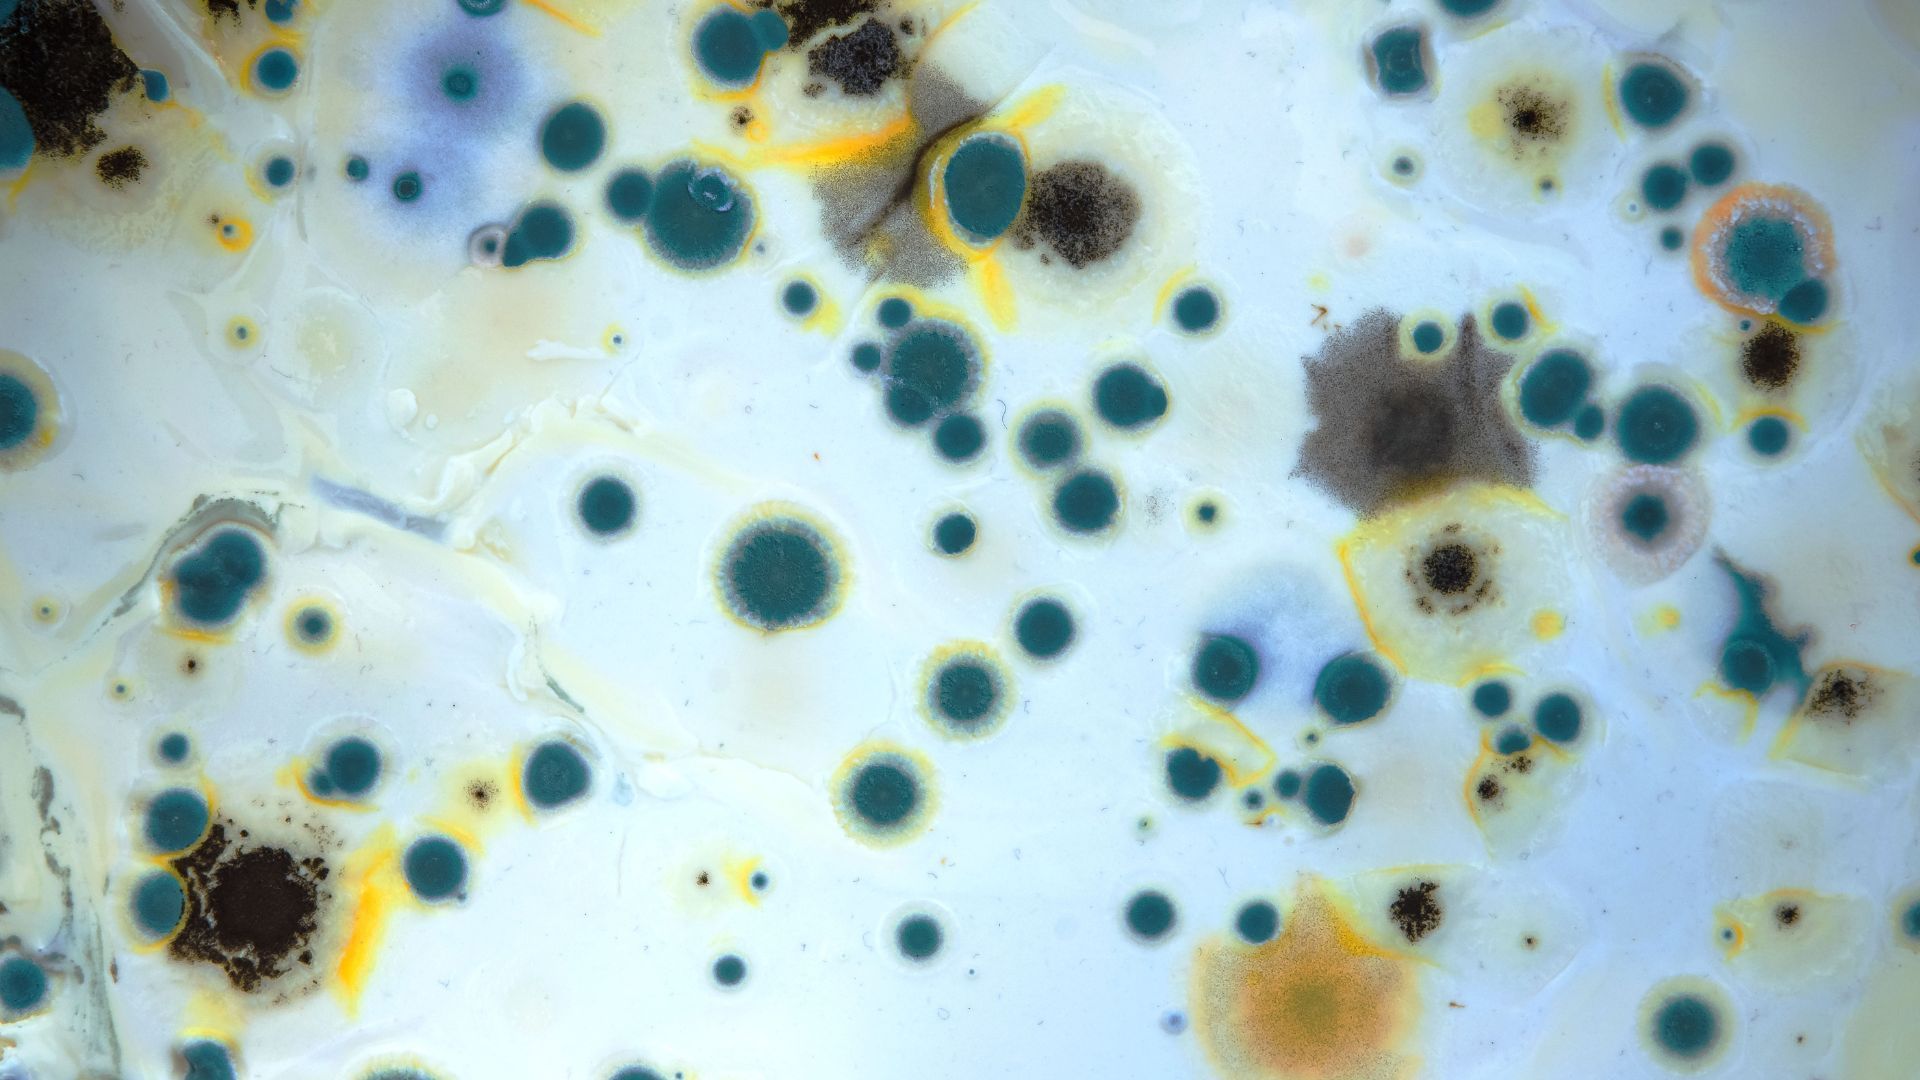
a close up of a mould growing on a white surface under a microscope .

Health Risks of Mold - Mold Free Main
Understanding Mold and Health
Mold is a common but often overlooked issue in homes. It's vital to understand the health risks it poses, as different molds can affect air quality and health. Awareness and education about these risks are key to maintaining a safe and healthy living environment.
Unveiling the Hidden Hazards, Safeguarding Your Health

Seeking Professional Help
Persistent health issues related to mold require medical attention. Additionally, professional mold remediation is crucial to address mold infestations effectively and safely.
If you suspect mold in your property, don’t wait. Contact us for a comprehensive mold inspection and expert remediation services.